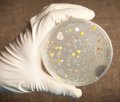
a Petri Dish

Get Healthy & Stay Healthy
There are ways to save on healthcare costs, and save the integrity of your health at the same time. It will be of immense value to you to investigate how you might avoid the toxicity of pharmaceuticals. Do you really need to run off to the doctor's office every time something just doesn't feel right or work as it should? What's their track record? How often do they beat the percentages achieved by a PLACEBO?
What are your Symptoms?
It is very possible for our comments to be considered as only personal opinion, but it is opinion shared by hundreds, and thousands of serious−minded people. The term, "Consensus Medicine," refers to the fact that many doctors and medical professionals adhere to, and concur with, a set of opinions they learned from other doctors and medical professionals.
There may be instances when Drugs, Surgery and Invasive Tests ("Consensus Medicine") are really the best thing to bring us back from the brink of death. Also, certain troubles simply require surgery, as in specific disfigurements and maladies from birth or injury. In any other instance, though, we try to stay away from Drugs, Surgery and Invasive Tests whenever possible. Even in the worst of those cases, it is likely still better to find an alternative treatment.
Here is a link to a webpage listing side effects of many medications. This page is on another website, and it is describing typical and possible side effects of using various drugs:In that page of the DRUGS.com website, there are details for many drugs. In our pages here, we discuss many Symptoms that people experience, and what Deficiency or Toxin may be the cause. As Experimenters and Researchers into effective methods and remedies, we'll try here to show you some of what we have discovered, and how to use them.
Our Immune Systems
We would not have survived as a species if we did not have a strong immune system. There are a number of systems in our body to deal with threats to our health, and most of us do not see them as such. Too often, all bacteria are considered in the same way, but we need to differentiate the bad from the good!
There are White Blood Cells that seek−out and destroy pathogens that get into our blood stream and other places. Our Lymph System plays a part in this as well, because the bad things need to be carried away from the organs and systems of our bodies. The liver does not even allow a certain amount of things we eat and drink to enter our blood stream by screening them out! We need to consider what we consume, remembering this fact, and how we should not overload the liver that is handling these tasks.
It is very important to realize that good bacteria in our gut comprises 90% of our immune defenses. Much of the trouble we suffer is because we have allowed this aspect of our bodies to be neglected, become weak, and to be overrun with bad microbes.
Carefully study the ways this can be corrected and directed to eliminate the most common things that cause so much disease and disorder in our bodies.
Wish to have a healthy child?
Consider the following suggestions as a good place to start for a healthy life:
-Mother should not use any prescription medications during pregnancy or nursing (especially not antibiotics)
-Mother should not have Amalgum Fillings in her teeth during pregnancy or nursing (have any safely removed if possible)
-Mother should not be Vitamin D deficient during pregnancy (should have a little time in the sun daily)
-Child should be born by natural, vaginal birth (at home if possible)
-Child should be breast fed by mother for at least 8 months (longer if possible)
-Child should never be treated with strong medications
-Child should never be given vaccinations
-Child should never be treated with oral antibiotics
Antibiotics are the main cause (or contributing factor) of chronic diseases like: candidiasis, chronic diarrhea, constipation, chronic clostridium difficile infection (C-Diff,) eczema, bad body odor, leaky gut syndrome, psoriasis, chronic acne, peeling lips, digestive problems, irritable bowel syndrome (IBS,) inflammatory bowel disease (IBD,) Parkinson's disease, Multiple Sclerosis, etc.
-Child should never have any surgical procedure (if avoidable)
-Child should be having regular bowel movements (1-2 per day)
-Be of a healthy color (brown - brown yellow feces)
-Have a healthy smell (not too strong of a smell)
-Have a healthy shape (nicely formed, rounded, not too large, not too small)
-Check child's diet if this is not the case
-Child should not ever get addicted to any drugs (as happens with ADD/ADHD Drugs)
-Child should not travel to third-world, tropical countries
Children born of mothers who had low levels of Vitamins D and E had an increased risk of developing asthma by age 10. As noted by "Lung Disease News":"The long follow-up is important as it shows that the pregnant woman's diet is important throughout the life of her child."There are good reasons for each of these things, and a lifetime of EXPENSE and SUFFERING may be avoided by adherance to the suggestions listed. Consider, also, the many other useful ways to keep healthy that are explained on this website.
Toxic Substances
A very important concern for us is TOXCITY, the damage it causes, how to avoid it and how to rid our bodies of it once we have a certain level of build−up in our tissues. Toxins are added to our drinking water and our food in alarming manners, and maybe, for questionable intents and purposes!
All our chemicals are poisonous when taken in too large a quantity. Some people have even died from drinking too much water. Almost all of pharmaceutical medicines are extremely poisonous, and become dangerous in sufficient quantities, and they all have some level of undesirable side effects, even when used as prescribed. One half of a cup of most of the chemicals in your home would be enough to kill you.
Long ago, I read something about this, and how the author believed MOST disease and disorder was the result of Toxins in our body, and how that Prescription and Non−Prescription Drugs were the "number one" source of these toxins. There are other sources, and we may learn ways to avoid most of this.
Some will build-up over time, and we do not need a massive dose to kill us or make us sick. This build-up shows as slowly degenerating health conditions, or the advent of disease and disorder. It is generally possible to DETOXIFY our bodies of many of these things.
Vitamin & Mineral Deficiency
Someone else, who had studied these things extensively, has stated that all disease and disorder is from some deficiency of vitamins, minerals, enzymes or other vital nutrients. That's really not the whole picture, but we can easily see a very specific pattern develop as we look into the causes, and successful treatments, of many diseases and disorders. We should address these factors immediately, and avoid further degradation of our health.
In our pages, we address major areas of deficiency for most people and are common to us as a population. Any person may need to address a specific deficiency.  Do not forget that being alerted to the problem is only the beginning, and you should seek help for your own specific situation with a Health Professional.
Successful Remedies
There are many simple ways to take good care of yourself, and avoid the dangers and toxic elements to which we are so often exposed. These things may be even used on a sporatic basis, or in a less than effective manner, but we can learn methods for correcting problems on our own.
There is good, bad, and even mediocre, in all things. Seek out sources for good quality supplements at reasonable prices. Availability, price and usefulness are important when trying to address problems we may have been experiencing acutely or for a long time.
As we find it pertinent, we will try to point you in the right direction, and give you good sources for the things that will help you. Over the years, we have paid about 50 times as much for a similar thing as compared to what it costs for our most recent find. There are variations in these products, but we may find one to be affordable, but not another!
Disclaimer
Our pages are reports of the findings from detailed study by a number of doctors. They may contain anecdotal information from other sources as well. These suggestions are provided for informational and educational purposes only, and should NOT be considered as medical advice. None of this information is intended to diagnose or treat a apecific illness or injury, as we are researchers, and not practicing any form of medicine.
We disclaim responsibility for injury or damage arising from any failure or omission in using any of the information shown on these pages. Use of this information and these suggestions is at your own risk and responsibility.
Be sure you heed and follow all instruction, recommendations and warnings as you experiment with the suggestions you get from reading these pages and any other pages referenced on this website. There are safety precautions associated with the instructions, and these should be heeded before starting to use anything you might learn from these pages. Failure to do so may result in injury to persons and/or damage to property.
Absence of any specific warning related to any specific form of carelessness or misuse does not mean that it is safe to use any particular supplement, device or protocol under all circumstances, or that one of these may be used in combination with another.
CommonSenseRemedies.com is not responsible for the content of websites that may be linked from these pages. Reasonable efforts are made to screen the content, before linking, but the info there is not related to CommonSenseRemedies.com and is not controlled by CommonSenseRemedies.com because these other pages are generated by other entities. Also, they may change their content, and we may not be aware of that.
Government regulations state you must consult a medical doctor for any disease. Government regulators consider testimonials to be misleading and deceptive. Please, understand that results and claims are not typical, and will vary from person to person or from case to case. We do not make specific claims using the information cited here. Any results described are not to be construed as typical results, and there is no guarantee to be implied of suitability or medically indicated treatment for any particular person or any particular case. You should consult a medical professional before taking any of these supplements, or attempting to use any of the devices or protocols referenced or suggested here.
Some substances can be FATAL (Deadly, Poisonous) if taken in the wrong dosage. Certain medical conditions may cause bad reactions to certain supplements. The books and other information referenced on this page were written or discussed by doctors that have studied the treatment of disease and disorder. They are the medical professionals. Seek the advice of these professionals, and NOT CommonSenseRemedies.com when you need medical advice.
Home
Get Healthy!
Mercury
CommonSenseRemedies.com